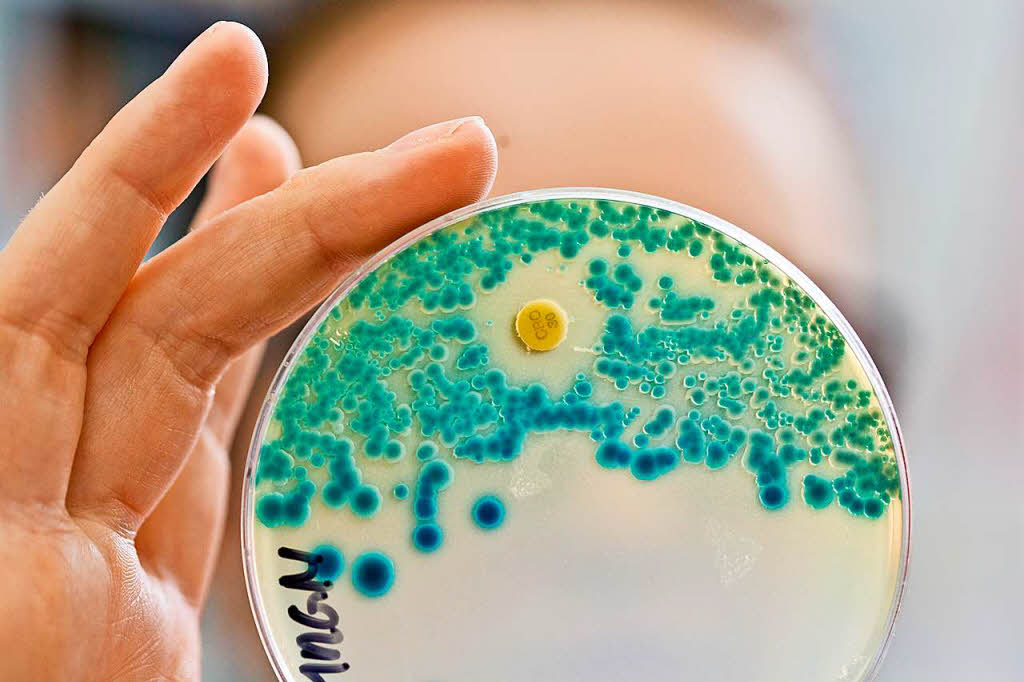
Bakterien sind immer öfter gegen Antibiotika resistent Panorama

Le mot antibactérien (du latin anti : « contre » et bacteria : « bactérie ») relatif à la lutte contre le développement de bactéries diffère de sens selon qu'on l'emploie comme adjectif ou comme nom.
Adjectif
L'adjectif « antibactérien » a conservé son sens premier et propre. Il qualifie tout ce qui sert[pas clair] à lutter contre les bactéries, agents de très nombreuses maladies infectieuses telles que le choléra, la légionellose, la lèpre, la syphilis, le tétanos, la tuberculose ou le typhus.
Nom
Un antibactérien est une substance ou un dispositif clinique qui permet soit de détruire les bactéries affectant le patient soit d'empêcher la multiplication des bactéries.
Dans le premier cas, on parle d'antibactérien bactéricide et dans le second cas d'antibactérien bactériostatique.
Les trois premiers types d'antibactériens ci-après sont nommés antibiotiques.
Antibactérien d'origine végétale
La pénicilline provient du champignons Penicillium notatum.
Antibactérien d'origine bactérienne
Dans le vivant, les bactéries sont en concurrence et parfois des bactéries produisent certaines molécules pour détruire d'autres bactéries.
La thyrothricine est obtenue à partir de la bactérie bacillus subtilis ; la streptomycine est isolée à partir de Streptomyces griseus; l'érythromycine est produite par une souche de Saccharopolyspora_erythraea; la vancomycine est isolée à partir de Amycolatopsis orientalis.
Antibactérien d'origine fossile
La quinolone est dérivée de la quinoléine qui a été extraite pour la première fois par Ferdinand Runge en 1834 du goudron de houille.
Antibactérien d'origine animale
Avec l'importance grandissante de la résistance des bactéries aux antibiotiques – les antibactériens décrits ci-dessus – les chercheurs et praticiens découvrent des antibactériens parfois présents dans des substances connues depuis longtemps.
C'est le cas de substances contenues dans le miel qui s'avère être un antibactérien à usage externe efficace contre, en particulier, Bacillus subtilis, Escherichia coli, les staphylocoques dorés, Pseudomonas aeruginosa et Enterococcus faecium. L'effet antibactérien du miel est dû à une multiplicité de facteurs.
Antibactérien naturel viral
Dans la nature on le nomme bactériophage, lorsqu'il est préparé comme dispositif clinique il est nommé bactériophagique.
L'utilisation des bactériophages pour combattre les bactéries est millénaire. L'exemple cité est celui des eaux de la rivière Yamuna étudié par le médecin militaire britannique Ernest Hankin.
Composés végétaux antibactériens
En raison également de la multiplication des bactéries multirésistantes, les recherches sur les plantes et extraits de plantes à vertu antibactérienne se multiplient.
Déjà en 1884, l'origan du Comtat, composé de 64 plantes dont la marjolaine et l'origan, avait été testé afin de protéger ses utilisateurs d'une épidémie de choléra.
Code ATC
Dans la Classification anatomique, thérapeutique et chimique (ATC) utilisée par l'Organisation mondiale de la santé, les agents antibactériens sont répertoriés sous le code J01, parmi les anti-infectieux systémiques (lettre J).
Notes et références
Articles connexes
- Maladie infectieuse
- Antibiotique
- Antimicrobien
- Antiseptique
- Asepsie
- Désinfection
- Portail de la médecine
- Portail de la biologie